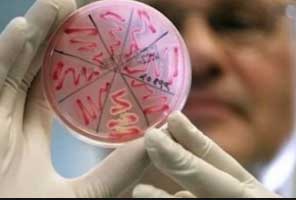
микробы

Бытует ошибочное мнение, что менингит относится к группе простудных заболеваний. Надев на малыша теплую шапку, от этой патологии защититься не удастся. Воспалительный процесс в оболочках мозга начинается при проникновении возбудителя заболевания в организм.
Прививка от менингита детям ставится в целях профилактики. Процедура помогает избежать нежелательных изменений и развития осложнений.
Опасность менингита
Менингит – это воспаление, поражающее головной, спинной мозг. Заболевание крайне опасно, способно спровоцировать серьезные осложнения, стать причиной смерти.
Заразиться можно даже от здорового человека, который является носителем инфекции. Риск инфицирования существенно повышается при посещении детских садов, школ.
Если заражения избежать не удастся, дальнейшая судьба малыша напрямую зависит от своевременно начатой терапии. Болезнь приводит к печальным последствиям. Как минимум это постоянные головные боли, психические нарушения. Зачастую заболевание ведет к инвалидности и летальному исходу.
Врачи подчеркивают важность вакцинации детей от менингококковой инфекции, особенно в раннем возрасте. Рекомендуется начинать вакцинацию с 2-месячного возраста, что позволяет создать защиту в период, когда дети наиболее уязвимы. Специалисты отмечают, что вакцинация может проводиться в несколько этапов, с ревакцинацией в дальнейшем, что обеспечивает длительный иммунный ответ.
Что касается реакции организма, то большинство детей переносят вакцинацию хорошо. Возможны легкие побочные эффекты, такие как покраснение в месте инъекции, небольшая температура или недомогание, которые обычно проходят в течение нескольких дней. Врачи акцентируют внимание на том, что серьезные осложнения крайне редки, и польза от вакцинации значительно превышает риски. Регулярные консультации с педиатром помогут родителям лучше понять процесс и подготовиться к вакцинации.
https://youtube.com/watch?v=00YODFaBzU8
Нужна ли прививка от менингита
Прививка от менингококковой инфекции не включена в обязательный календарь иммунизации. Массовую вакцинацию проводят по эпидемиологическим показаниям.
При отсутствии вспышки заболеваемости эту процедуру рекомендуется проводить следующим группам детей:
- с иммунодефицитом;
- после пересадки костного мозга;
- при удаленной вилочковой железе, селезенки;
- во время хронических патологий органов дыхания;
- малышам в возрасте 1,5-2 года посещающим детский сад;
- при контакте с носителем инфекции;
- если в детском коллективе появился ребенок с подозрением на менингит.
В группу риска входят дети с трех месяцев до пяти лет. Поэтому их рекомендуется прививать независимо от того, есть эпидемия или нет.
В каком возрасте проводится иммунизация
Впервые детская прививка ставится грудничкам на первом году жизни. Также пройти иммунизацию рекомендуется пятилетним детям. Еще одна доза вакцины вводится уже по достижению четырнадцатилетнего возраста.
Вакцинация детей от менингококковой инфекции вызывает множество обсуждений среди родителей и медицинских специалистов. Многие родители отмечают, что прививка помогает защитить их детей от серьезных заболеваний, которые могут привести к тяжелым последствиям. Сроки вакцинации варьируются в зависимости от рекомендаций врачей и национальных программ иммунизации, но чаще всего прививки делают в раннем возрасте.
Некоторые родители выражают опасения по поводу возможных реакций организма на вакцину. Чаще всего наблюдаются легкие побочные эффекты, такие как покраснение в месте укола, небольшая температура или слабость. Однако большинство специалистов подчеркивают, что эти реакции являются нормальными и свидетельствуют о том, что иммунная система активно реагирует на введенный антиген. Важно, чтобы родители обсуждали все вопросы и сомнения с педиатрами, чтобы принимать обоснованные решения о здоровье своих детей.
https://youtube.com/watch?v=crIecaf5Jec
График вакцинации
Новорожденным вакцинация не нужна. До трехмесячного возраста у них в организме находятся антитела, полученные от матери. Поэтому первую прививку рекомендуется ставить вместе с АКДС (по достижению малышом трех месяцев). При этом схема вакцинации подразумевает введение препарата трижды.

При выполнении процедуры с полугодовалого возраста до года иммунитет помогут выработать всего две инъекции. Между ними выдерживают интервал два месяца. Ревакцинация также проводится спустя год.
Детям старше года препарат вводят однократно. Повторно процедура выполняется спустя пятилетие.
Виды применяемых вакцин
Воспаление оболочки головного мозга наблюдается вследствие проникновения грибков, бактерий, вирусов, простейших. Поэтому универсального препарата, способного предотвратить начало патологического процесса, нет.
Профилактика менингита проводится с помощью следующих разновидностей медикаментов:
- Против менингококкового менингита. Применяется уже продолжительное время, переносится хорошо. Бывает двух, трех, четырех валентной.
- Против гемофильного менингита. Способствует выработке антител к патологии, развитие которой провоцирует гемофильная инфекция.
- Против пневмококкового менингита.
https://youtube.com/watch?v=hO1FHprznNc
Названия используемых вакцин
Вакцина против менингита называется по-разному.
Среди препаратов, призванных защитить от менингита выделяют следующие:
- Вакцину менингококковую. Сыворотка отечественного производства. Предотвращает поражение организма менингококками серотипов С, А. Не способна защитить от гнойной менингококковой инфекции. Применяется для вакцинации детей с полуторагодовалого возраста.
Менинго А+С. Изготавливается Францией. Способен предотвратить поражение цереброспинальным менингитом. Медикамент допускается вводить, начиная с полутора лет.
- Менцевакс ACWY. Медикамент бельгийского производства. Создает защитный барьер к инфекции, провоцируемой серотипами A, C, W, Y. Применяется для вакцинации детей старше двух лет.
- Менактру. Производится фармакологическими компаниями США. Формирует иммунитет к серотипам А, С, Y и W-135. Допускается вакцинация детей с двухлетнего возраста.
Препараты против менингококковой инфекции выпускают в виде порошка. Его растворяют непосредственно перед постановкой прививки. Укол делают внутримышечно, подкожно.
Чтобы предотвратить развитие гемофильной инфекции, используется вакцина АКТ-ХИБ. Создан медикамент из клеточных стенок возбудителя. Это сухой порошок. Его разводят специальным растворителем перед иммунизацией.
От гемофильной палочки защищает также Тетракок. Помимо этого, сыворотка защищает от столбняка, дифтерии, коклюша, полиомиелита. Постановка прививки выполняется внутримышечно. Местом укола выступает плечо, бедро.
С целью предотвращения пневмококкового менингита применяются следующие вакцины:
- Пневмо 23, производится Францией, препарат допускается вводить детям старше двух лет;
- Превенар 13, вакцинация проводится с двухмесячного возраста.
Принцип действия препарата
После введения препарата возбудитель инфекции проникает в кровоток. Сразу активизируются защитные функции организма. Иммунитет начинает активный синтез антител к инородному веществу.
Таким образом за короткое время создается барьер, препятствующий развитию патогенных микроорганизмов. В дальнейшем при проникновении возбудителя организм оказывается способен ему противостоять.
Антитела в крови отмечаются уже спустя сутки после проведения вакцинации. Должной для полноценной защиты концентрации они достигают лишь спустя две недели.
Срок действия вакцины
Антитела, выработанные иммунной системой, в большой концентрации сохраняются до пяти лет. Спустя этот промежуток времени вакцинацию рекомендуется проводить повторно. Организм уже не способен защитить от начала патологического процесса.
Возможные побочные эффекты
Заблаговременно предугадать, как детский организм отреагирует на введенную вакцину, невозможно. Отмечено, что зачастую при строгом соблюдении всех врачебных рекомендаций, побочные действия препарата не наблюдаются. Дети переносят поствакцинальный период легко.
Иногда отмечают следующие побочные эффекты:
- общее недомогание;
- незначительный подъем температуры;
- слабость;
плаксивость;
- апатию;
- побледнение кожного покрова;
- раздражительность;
- головные боли;
- потерю аппетита;
- болезненность мышц, суставов;
- нарушения сна (чрезмерная сонливость, инсомния);
- покраснение, отечность места укола;
- болезненность пораженной области;
- высыпания на коже.
Подобные изменения считаются естественной реакцией организма на введенную сыворотку. Спустя 2-3 суток неприятная симптоматика исчезает. При повышении температуры ребенку рекомендуется дать жаропонижающее средство на основе ибупрофена, парацетамола.
Отечность, покраснение пораженной области наблюдается максимум две недели. Никаких мер принимать не нужно.
Категорически запрещено обрабатывать место укола антисептическими средствами, мазями, растворами, заклеивать пластырем. Такие действия способны привести к усугублению ситуации. Также нельзя тереть, расчесывать место введения препарата. Существует риск проникновения вторичной инфекции.
Осложнения
Редко отмечаются осложнения после иммунизации. Негативные изменения, как правило, обусловлены пренебрежением существующими противопоказаниями, несоблюдением врачебных рекомендаций.
Возможны следующие последствия постановки вакцины:
- отек Квинке;
- обострение патологий, протекающих в хронической форме;
- анафилактический шок;
- стремительное ухудшение состояния;
- гипертермия;
- головокружение;
- судорожный синдром;
крапивница;
- отечность ротовой полости;
- тахикардия;
- проблемы с дыханием;
- одышка, сопровождающаяся хрипами.
Подобные изменения нельзя оставлять без внимания. При их появлении нужно без промедления обращаться за помощью к педиатру.
Противопоказания
Иммунизация выполняется по желанию родителей, а также в случае наличия показаний к этой процедуре. Несмотря на это, иногда приходится отказаться от введения сыворотки ребенку.
Среди противопоказаний к проведению вакцинации выделяют следующие:
- аллергическую реакцию на составляющие используемого медикамента;
- ярко выраженную реакцию на ранее введенный препарат (ревакцинация при этом не выполняется);
- обострение болезней, протекающих в острой форме;
- острые заболевания (процедуру откладывают до полного выздоровление малыша).
Во всех остальных случаях никаких преград для вакцинации нет. Нужно пройти осмотр у педиатра и после этого отправляться в прививочный кабинет.
Проводить вакцинацию или нет
Решение о рациональности проведения вакцинации должны принимать родители. Нужно взвесить все “за” и “против”, соизмерить соотношение пользы с риском. Также следует учитывать состояние здоровья малыша, ряд других факторов.
Чтобы определиться, во внимание нужно брать следующие аргументы:
- вакцинация рекомендована, если кто-то из родителей болел менингитом, будучи ребенком;
- прививка способна защитить от воспаления оболочек мозга, а также от ряда патологий дыхательных путей;
- эффективность иммунизации достигает 95-100%, переносится процедура легко;
- вакцину нужно вводить обязательно при планировании поездки в Африку, Канаду, другие эпидемические районы;
- выявить наличие бактерий сложно, нередко врачи не могут отличить назофарингит, развивающийся при менингите, от других воспалительных процессов;
- прививка – самый надежный способ профилактики опасного заболевания.
Лечить не привитого ребенка оказывается проблематично. Последствия болезни оказываются весьма плачевными. Ребенок может остаться инвалидом. Не исключается смертельный исход.
Вопрос-ответ
Как переносится прививка от менингококковой инфекции?
Вакцина Менактра хорошо переносится. Реакции легкие и могут продолжаться менее 3 суток. В основном это болезненность и покраснение в месте укола, потеря аппетита, раздражительность, сонливость, может быть рвота. Все это пройдет самостоятельно.
Когда начинает действовать прививка от менингита?
В ходе исследований доказано, что более чем у 90% вакцинированных формируется адекватный иммунный ответ против менингококка через 7–10 дней после иммунизации. Иммунитет после вакцинации сохраняется в среднем на 5 лет.
Какая может быть реакция на прививку от менингита?
Возможные реакции. Вакцина «Менактра» является неживой. Возможные реакции на нее проявляются в первые двое суток после прививки и проходят в течение 2-3 дней. Нормальными реакциями на введение вакцины являются местная реакция: покраснение, отек, боль и повышение температуры кожи в месте инъекции.
Как выглядит аллергическая реакция на вакцину от менингита?
Если вы заметили признаки тяжелой аллергической реакции (крапивницу, отек лица и горла, затрудненное дыхание, учащенное сердцебиение, головокружение или слабость), позвоните по номеру 9-1-1 и доставьте человека в ближайшую больницу.
Советы
СОВЕТ №1
Перед вакцинацией обязательно проконсультируйтесь с педиатром. Врач поможет оценить состояние здоровья вашего ребенка и даст рекомендации по выбору времени для прививки, учитывая индивидуальные особенности.
СОВЕТ №2
Обратите внимание на календарь прививок. Вакцинация от менингококковой инфекции обычно проводится в определенные сроки, поэтому важно следить за графиком и не пропускать запланированные даты.
СОВЕТ №3
После вакцинации наблюдайте за реакцией организма ребенка. Легкие побочные эффекты, такие как покраснение или небольшая температура, могут быть нормой. Однако, если вы заметите серьезные изменения в состоянии здоровья, немедленно обратитесь к врачу.
СОВЕТ №4
Обсудите с врачом возможные противопоказания и аллергические реакции. Если у вашего ребенка есть аллергия на какие-либо компоненты вакцины, это важно учитывать при принятии решения о вакцинации.


Менинго А+С. Изготавливается Францией. Способен предотвратить поражение цереброспинальным менингитом. Медикамент допускается вводить, начиная с полутора лет.

плаксивость;
крапивница;
